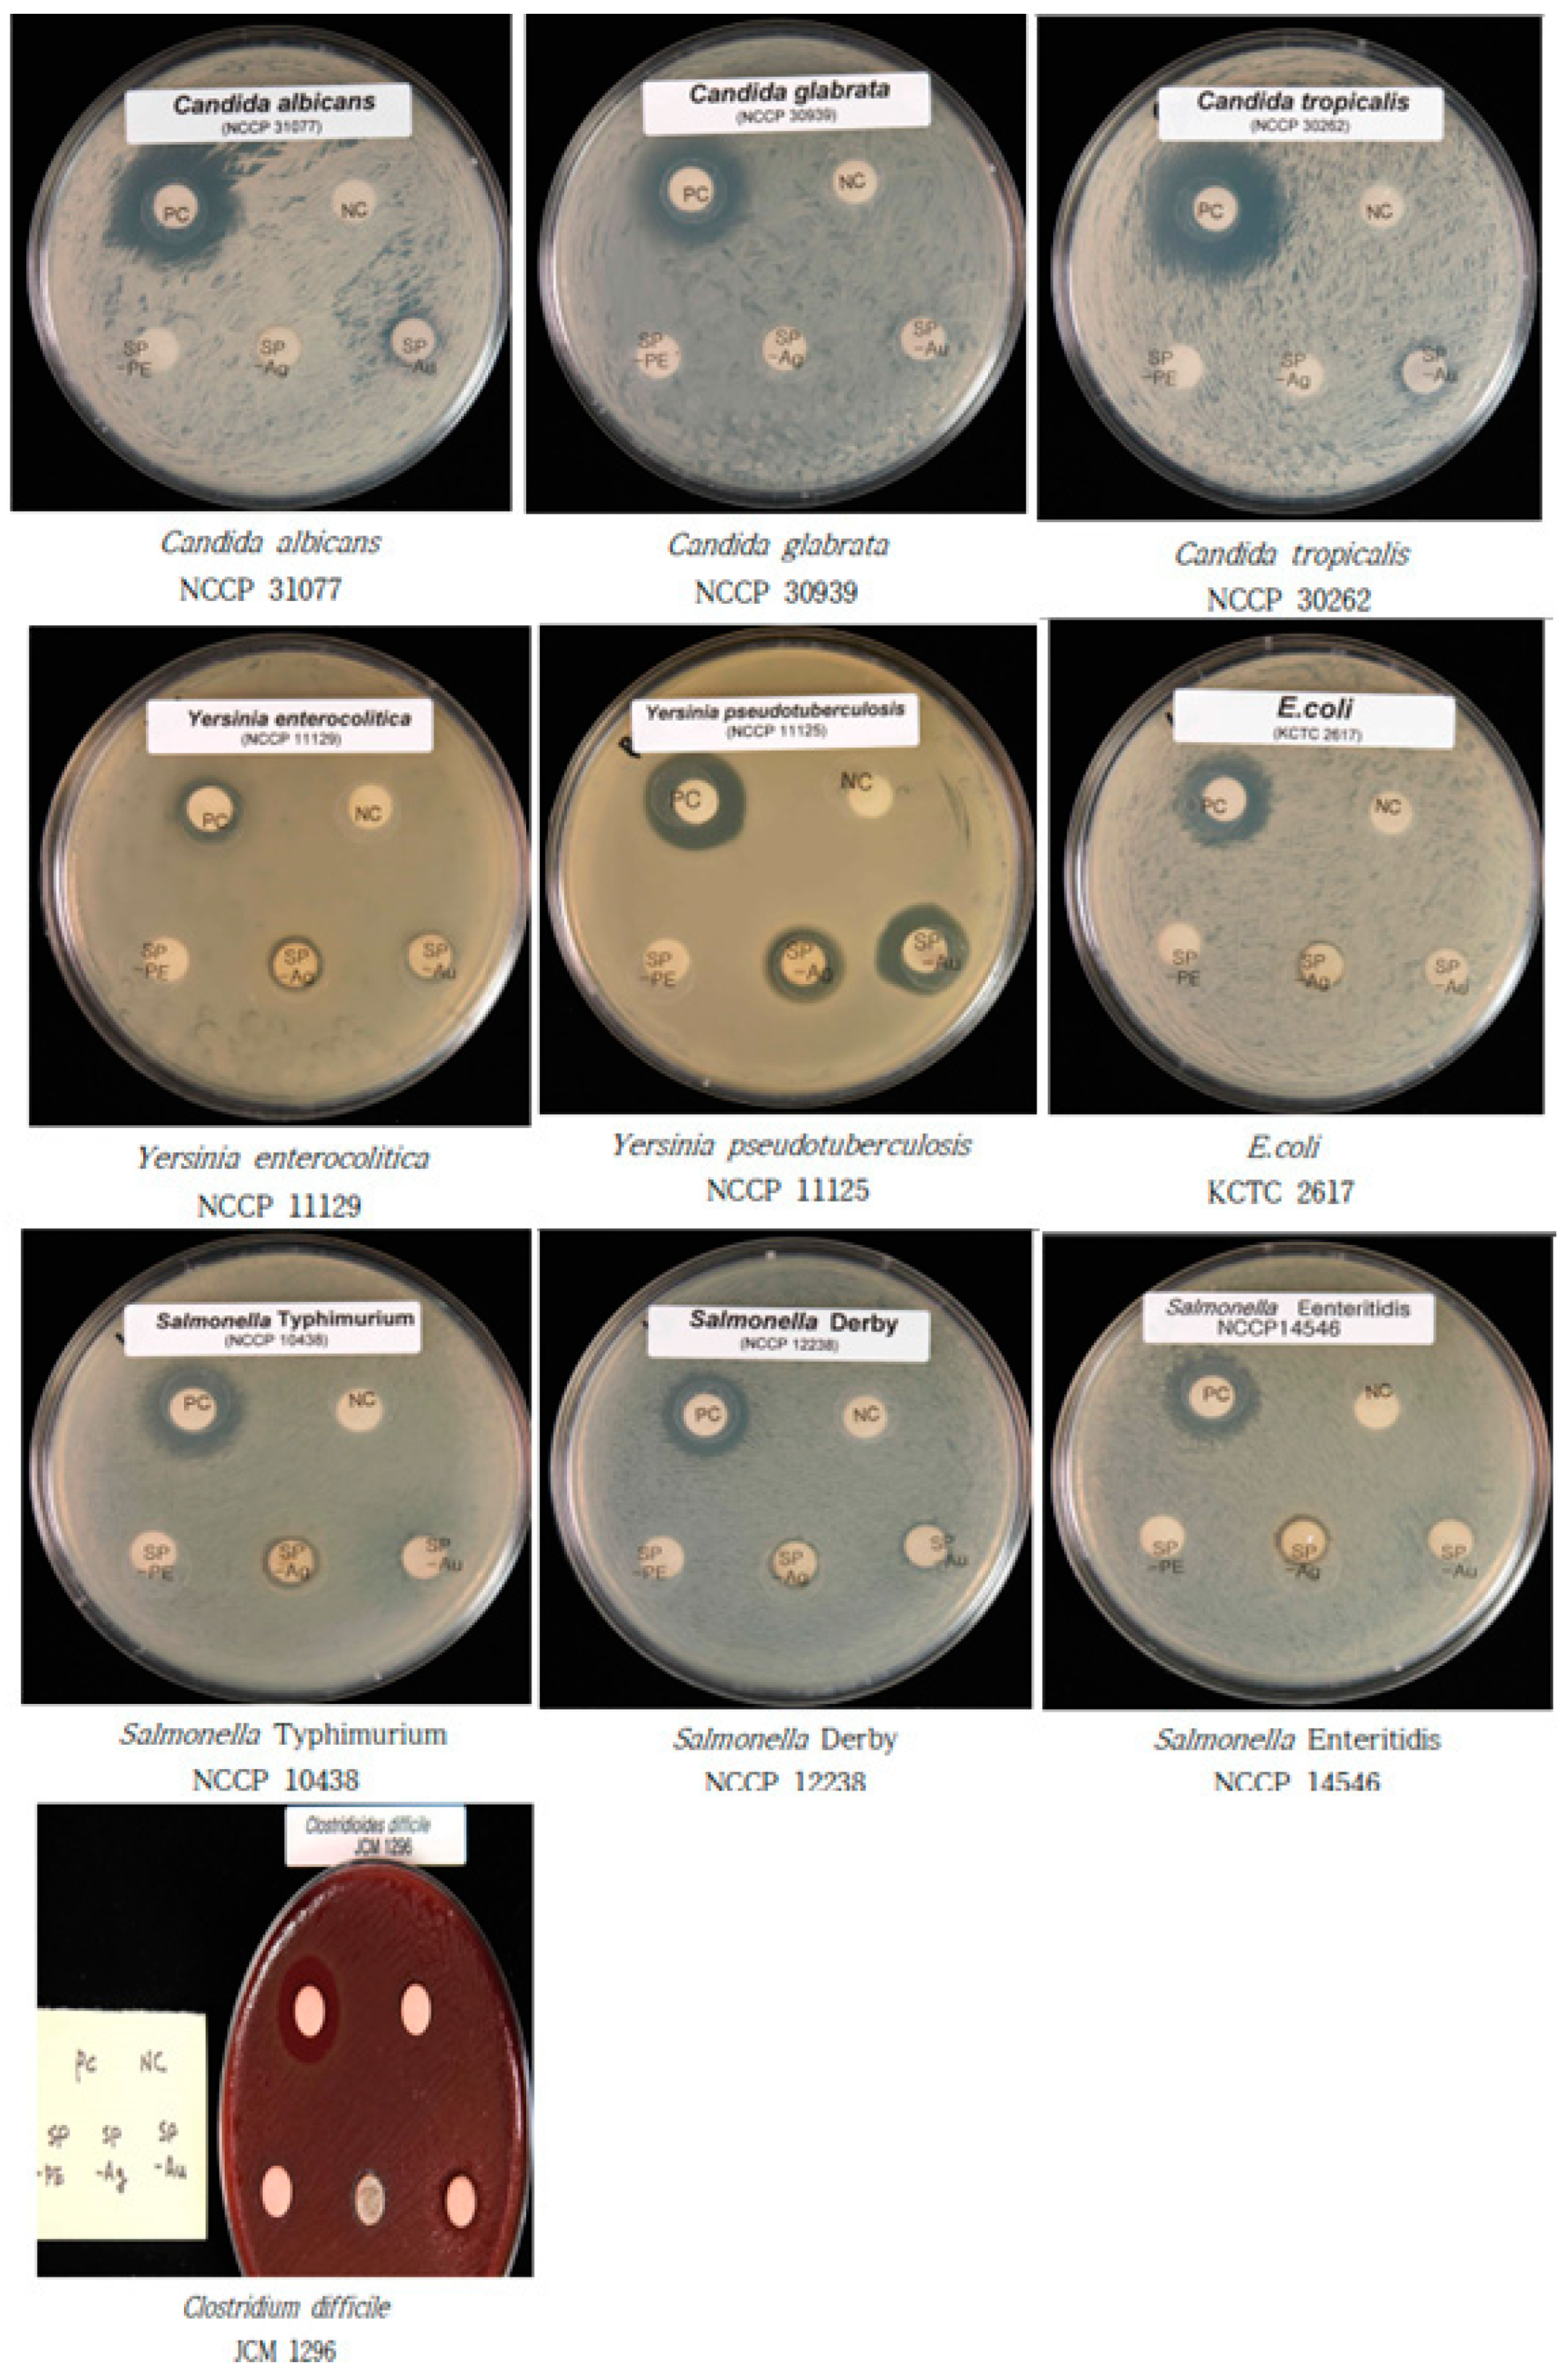
Antibiotics 12 00507 g006 Antibiotics 12 00507 g006

Sedeveria pink ruby Extract-Mediated Synthesis of Gold and Silver Nanoparticles and Their Bioactivity against Livestock Pathogens and in Different Cell Lines
Abstract
1. Introduction
2. Results and Discussion
2.1. UV–Visible (UV–Vis) Spectrophotometry of SP-AuNPs and SP-AgNPs
2.2. FESEM-EDX Characterization of SP-AuNPs and SP-AgNPs
2.3. Transmission Electron Microscopy (TEM) of SP-AuNPs and SP-AgNPs
2.4. AFM Characterization of SP-AuNPs and SP-AgNPs
2.5. FT-IR Spectroscopic Analysis of SP-AuNPs and SP-AgNPs
2.6. Powder XRD Characterization of SP-AuNPs and SP-AgNPs
2.7. Antibacterial Activity of SP-AuNPs and SP-AgNPs
2.8. Antifungal Activity of SP-AuNPs and SP-AgNPs
2.9. Antioxidant Activity of SP-AuNPs and SP-AgNPs
2.10. Cytotoxicity of SP-AuNPs and SP-AgNPs
3. Conclusions
4. Materials and Methods
4.1. Chemicals
4.2. Plant Collection and Preparation of Aqueous Extract
4.3. Biosynthesis of AuNPs and AgNPs
4.4. Characterization of SP-AuNPs and SP-AgNPs
4.5. Antibacterial Activity of SP-AuNPs and SP-AgNPs
4.6. Antifungal Activity of SP-AuNPs and SP-AgNPs
4.7. MIC Study
4.8. Antioxidant Activity of SP-AuNPs and SP-AgNPs
4.9. Cytotoxicity of SP-AuNPs and SP-AgNPs
4.10. Statistical Analysis
Supplementary Materials
Author Contributions
Funding
Institutional Review Board Statement
Informed Consent Statement
Data Availability Statement
Acknowledgments
Conflicts of Interest
References
- Song, J.Y.; Jang, H.; Kim, B.S. Biological synthesis of gold nanoparticles using Magnolia kobus and Diopyros kaki leaf extracts. Process Biochem. 2009, 44, 1133–1138. [Google Scholar] [CrossRef]
- Amjad, R.; Mubeen, B.; Ali, S.S.; Imam, S.S.; Alshehri, S.; Ghoneim, M.M.; Alzarea, S.I.; Rasool, R.; Ullah, I.; Nadeem, M.S.; et al. Green synthesis and characterization of copper nanoparticles using Fortunella margarita Leaves. Polymers 2021, 13, 4364. [Google Scholar] [CrossRef] [PubMed]
- Chouhan, N. Silver Nanoparticles: Synthesis, Characterization and Applications. In Silver Nanoparticles: Fabrication, Characterization and Applications; Maaz, K., Ed.; IntechOpen: London, UK, 2018. [Google Scholar] [CrossRef]
- Aabed, K.; Mohammed, A.E. Phytoproduct, arabic gum and Opophytum forsskalii seeds for bio-fabrication of silver nanoparticles: Antimicrobial and cytotoxic capabilities. Nanomaterials 2021, 11, 2573. [Google Scholar] [CrossRef]
- Banu, H.; Renuka, N.; Faheem, S.M.; Ismail, R.; Singh, V.; Saadatmand, Z.; Khan, S.S.; Narayanan, K.; Raheem, A.; Premkumar, K.; et al. Gold and Silver Nanoparticles Biomimetically Synthesized Using Date Palm Pollen Extract-Induce Apoptosis and Regulate p53 and Bcl-2 Expression in Human Breast Adenocarcinoma Cells. Biol. Trace Elem. Res. 2018, 186, 122–134. [Google Scholar] [CrossRef]
- Hemlata; Meena, P.R.; Singh, A.P.; Tejavath, K.K. Biosynthesis of Silver Nanoparticles Using Cucumis prophetarum Aqueous Leaf Extract and Their Antibacterial and Antiproliferative Activity against Cancer Cell Lines. ACS Omega 2020, 5, 5520–5528. [Google Scholar] [CrossRef] [PubMed]
- Nadagouda, M.N.; Iyanna, N.; Lalley, J.; Han, C.; Dionysiou, D.D.; Varma, R.S. Synthesis of silver and gold nanoparticles using antioxidants from blackberry, blueberry, pomegranate, and turmeric extracts. ACS Sustain. Chem. Eng. 2014, 2, 1717–1723. [Google Scholar] [CrossRef]
- Patil, M.P.; Kim, J.O.; Seo, Y.B.; Kang, M.J.; Kim, G.D. Biogenic Synthesis of Metallic Nanoparticles and Their Antibacterial Applications Biogenic Synthesis of Metallic Nanoparticles and Their Antibacterial Applications. J. Life Sci. 2021, 31, 862–872. [Google Scholar]
- Da Silva, A.L.; Santos, R.S.; Xisto, D.G.; Alonso, S.D.V.; Morales, M.M.; Rocco, P.R.M. Nanoparticle-based therapy for respiratory diseases. An. Acad. Bras. Ciências 2013, 85, 137–146. [Google Scholar] [CrossRef]
- Flores-Lopez, N.S.; Cervantes-Chávez, J.A.; Téllez de Jesús, D.G.; Cortez-Valadez, M.; Estévez-González, M.; Esparza, R. Bactericidal and fungicidal capacity of Ag2O/Ag nanoparticles synthesized with Aloe vera extract. J. Environ. Sci. Health Part A 2021, 56, 762–768. [Google Scholar] [CrossRef]
- Hernández-Díaz, J.A.; Garza-García, J.J.O.; Zamudio-Ojeda, A.; León-Morales, J.M.; López-Velázquez, J.C.; García-Morales, S. Plant-mediated synthesis of nanoparticles and their antimicrobial activity against phytopathogens. J. Sci. Food Agric. 2021, 101, 1270–1287. [Google Scholar] [CrossRef]
- Prasad, T.N.V.K.V.; Ek, E. Biofabrication of Ag nanoparticles using Moringa oleifera leaf extract and their antimicrobial activity. Asian Pac. J. Trop. Biomed. 2011, 6, 439–442. [Google Scholar] [CrossRef] [PubMed]
- Ssekatawa, K.; Byarugaba, D.K.; Kato, C.D.; Wampande, E.M.; Ejobi, F.; Nakavuma, J.L.; Maaza, M.; Sackey, J.; Nxumalo, E.; Kirabira, J.B. Green Strategy–Based Synthesis of Silver Nanoparticles for Antibacterial Applications. Front. Nanotechnol. 2021, 3, 697303. [Google Scholar] [CrossRef]
- Kumari, M.M.; Philip, D. Facile one-pot synthesis of gold and silver nanocatalysts using edible coconut oil. Spectrochim. Acta Part A Mol. Biomol. Spectrosc. 2013, 111, 154–160. [Google Scholar] [CrossRef]
- Perevedentseva, E.; Ali, N.; Lin, Y.-C.; Karmenyan, A.; Chang, C.-C.; Bibikova, O.; Skovorodkin, I.; Prunskaite-Hyyryläinen, R.; Vainio, S.J.; Kinnunen, M.; et al. Au nanostar nanoparticle as a bio-imaging agent and its detection and visualization in biosystems. Biomed. Opt. Express 2020, 11, 5872. [Google Scholar] [CrossRef] [PubMed]
- Si, P.; Razmi, N.; Nur, O.; Solanki, S.; Pandey, C.M.; Gupta, R.K.; Malhotra, B.D.; Willander, M.; De La Zerda, A. Gold nanomaterials for optical biosensing and bioimaging. Nanoscale Adv. 2021, 3, 2679–2698. [Google Scholar] [CrossRef]
- Acharya, D.; Satapathy, S.; Somu, P.; Parida, U.K.; Mishra, G. Apoptotic Effect and Anticancer Activity of Biosynthesized Silver Nanoparticles from Marine Algae Chaetomorpha linum Extract against Human Colon Cancer Cell HCT-116. Biol. Trace Elem. Res. 2021, 199, 1812–1822. [Google Scholar] [CrossRef]
- Eby, D.M.; Luckarift, H.R.; Johnson, G.R. Hybrid antimicrobial enzyme and silver nanoparticle coatings for medical instruments. ACS Appl. Mater. Interfaces 2009, 1, 1553–1560. [Google Scholar] [CrossRef]
- Hussain, J.I.; Kumar, S.; Hashmi, A.A.; Khan, Z. Silver nanoparticles: Preparation, characterization, and kinetics. Int. Assoc. Adv. Mater. 2011, 2, 188–194. [Google Scholar]
- Kapoor, S.; Sood, H.; Saxena, S.; Chaurasia, O.P. Green synthesis of silver nanoparticles using Rhodiola imbricata and Withania somnifera root extract and their potential catalytic, antioxidant, cytotoxic and growth-promoting activities. Bioprocess Biosyst. Eng. 2022, 45, 365–380. [Google Scholar] [CrossRef]
- Saif, S.; Tahir, A.; Chen, Y. Green Synthesis of Iron Nanoparticles and Their Environmental Applications and Implications. Nanomaterials 2016, 6, 209. [Google Scholar] [CrossRef]
- Guo, D.; Dou, D.; Ge, L.; Huang, Z.; Wang, L.; Gu, N. A caffeic acid mediated facile synthesis of silver nanoparticles with powerful anti-cancer activity. Colloids Surf. B Biointerfaces 2015, 134, 229–234. [Google Scholar] [CrossRef] [PubMed]
- Rónavári, A.; Igaz, N.; Adamecz, D.I.; Szerencsés, B.; Molnar, C.; Kónya, Z.; Pfeiffer, I.; Kiricsi, M. Green silver and gold nanoparticles: Biological synthesis approaches and potentials for biomedical applications. Molecules 2021, 26, 844. [Google Scholar] [CrossRef] [PubMed]
- Chandran, S.P.; Chaudhary, M.; Pasricha, R.; Ahmad, A.; Sastry, M. Synthesis of gold nanotriangles and silver nanoparticles using Aloe vera plant extract. Biotechnol. Prog. 2006, 22, 577–583. [Google Scholar] [CrossRef] [PubMed]
- Pulit, J.; Banach, M. Preparation of nanosilver and nanogold based on dog rose aqueous extract. Bioinorg. Chem. Appl. 2014, 2014, 658935. [Google Scholar] [CrossRef] [PubMed]
- Koul, B.; Poonia, A.K.; Yadav, D.; Jin, J.O. Microbe-mediated biosynthesis of nanoparticles: Applications and future prospects. Biomolecules 2021, 11, 886. [Google Scholar] [CrossRef] [PubMed]
- Shah, A.T.; Din, M.I.; Bashir, S.; Qadir, M.A.; Rashid, F. Green Synthesis and Characterization of Silver Nanoparticles Using Ferocactus echidne Extract as a Reducing Agent. Anal. Lett. 2015, 48, 1180–1189. [Google Scholar] [CrossRef]
- Huo, Y.; Singh, P.; Kim, Y.J.; Soshnikova, V.; Kang, J.; Markus, J.; Ahn, S.; Castro-Aceituno, V.; Mathiyalagan, R.; Chokkalingam, M.; et al. Biological synthesis of gold and silver chloride nanoparticles by Glycyrrhiza uralensis and in vitro applications. Artif. Cells Nanomed. Biotechnol. 2018, 46, 303–312. [Google Scholar] [CrossRef]
- Adewale, O.B.; Egbeyemi, K.A.; Onwuelu, J.O.; Potts-Johnson, S.S.; Anadozie, S.O.; Fadaka, A.O.; Osukoya, O.A.; Aluko, B.T.; Johnson, J.; Obafemi, T.O.; et al. Biological synthesis of gold and silver nanoparticles using leaf extracts of Crassocephalum rubens and their comparative in vitro antioxidant activities. Heliyon 2020, 6, e05501. [Google Scholar] [CrossRef]
- Chahardoli, A.; Hajmomeni, P.; Ghowsi, M.; Qalekhani, F.; Shokoohinia, Y.; Fattahi, A. Optimization of quercetin-assisted silver nanoparticles synthesis and evaluation of their hemocompatibility, antioxidant, anti-inflammatory, and antibacterial effects. Glob. Chall. 2021, 5, 2100075. [Google Scholar] [CrossRef]
- Khan, S.A.; Shahid, S.; Lee, C.S. Green synthesis of gold and silver nanoparticles using leaf extract of Clerodendrum inerme; characterization, antimicrobial, and antioxidant activities. Biomolecules 2020, 10, 835. [Google Scholar] [CrossRef]
- Fu, L.H.; Yang, J.; Zhu, J.F.; Ma, M.G. Synthesis of Gold Nanoparticles and Their Applications in Drug Delivery. In Metal Nanoparticles in Pharma; Springer: Berlin/Heidelberg, Germany, 2017; pp. 155–191. [Google Scholar]
- Singh, P.; Pandit, S.; Garnæs, J.; Tunjic, S.; Mokkapati, V.R.S.S.; Sultan, A.; Thygesen, A.; Mackevica, A.; Mateiu, R.V.; Daugaard, A.E.; et al. Green synthesis of gold and silver nanoparticles from Cannabis sativa (industrial hemp) and their capacity for biofilm inhibition. Int. J. Nanomed. 2018, 13, 3571–3591. [Google Scholar] [CrossRef]
- Jain, S.; Mehata, M.S. Medicinal Plant Leaf Extract and Pure Flavonoid Mediated Green Synthesis of Silver Nanoparticles and their Enhanced Antibacterial Property. Sci. Rep. 2017, 7, 15867. [Google Scholar] [CrossRef] [PubMed]
- Ponarulselvam, S.; Panneerselvam, C.; Murugan, K.; Aarthi, N.; Kalimuthu, K.; Thangamani, S. Synthesis of silver nanoparticles using leaves of Catharanthus roseus Linn. G. Don and their antiplasmodial activities. Asian Pac. J. Trop. Biomed. 2012, 2, 574–580. [Google Scholar]
- Kharey, P.; Dutta, S.B.; Gorey, A.; Manikandan, M.; Kumari, A.; Vasudevan, S.; Palani, I.A.; Majumder, S.K.; Gupta, S. Pimenta dioica Mediated Biosynthesis of Gold Nanoparticles and Evaluation of Its Potential for Theranostic Applications. ChemistrySelect 2020, 5, 7901–7908. [Google Scholar] [CrossRef]
- Doan, V.D.; Luc, V.S.; Nguyen, T.L.H.; Nguyen, T.D.; Nguyen, T.D. Utilizing waste corn-cob in biosynthesis of noble metallic nanoparticles for antibacterial effect and catalytic degradation of contaminants. Environ. Sci. Pollut. Res. 2020, 27, 6148–6162. [Google Scholar] [CrossRef]
- Kang, J.P.; Kim, Y.J.; Singh, P.; Huo, Y.; Soshnikova, V.; Markus, J.; Ahn, S.; Chokkalingam, M.; Lee, H.A.; Yang, D.C. Biosynthesis of gold and silver chloride nanoparticles mediated by Crataegus pinnatifida fruit extract: In Vitro study of anti-inflammatory activities. Artif. Cells Nanomed. Biotechnol. 2018, 46, 1530–1540. [Google Scholar] [CrossRef]
- Valsalam, S.; Agastian, P.; Esmail, G.A.; Ghilan, A.K.M.; Al-Dhabi, N.A.; Arasu, M.V. Biosynthesis of silver and gold nanoparticles using Musa acuminata colla flower and its pharmaceutical activity against bacteria and anticancer efficacy. J. Photochem. Photobiol. B Biol. 2019, 201, 111670. [Google Scholar] [CrossRef]
- Rautela, A.; Rani, J.; Debnath (Das), M. Green synthesis of silver nanoparticles from Tectona grandis seeds extract: Characterization and mechanism of antimicrobial action on different microorganisms. J. Anal. Sci. Technol. 2019, 10, 5. [Google Scholar] [CrossRef]
- Qu, D.; Sun, W.; Chen, Y.; Zhou, J.; Liu, C. Synthesis and in vitro antineoplastic evaluation of silver nanoparticles mediated by Agrimoniae herba extract. Int. J. Nanomed. 2014, 9, 1871–1882. [Google Scholar]
- Le, V.T.; Ngu, N.N.Q.; Chau, T.P.; Nguyen, T.D.; Nguyen, V.T.; Nguyen, T.L.H.; Cao, X.T.; Doan, V.D. Silver and Gold Nanoparticles from Limnophila rugosa Leaves: Biosynthesis, Characterization, and Catalytic Activity in Reduction of Nitrophenols. J. Nanomater. 2021, 2021, 5571663. [Google Scholar] [CrossRef]
- Francis, S.; Koshy, E.P.; Mathew, B. Green synthesis of Stereospermum suaveolens capped silver and gold nanoparticles and assessment of their innate antioxidant, antimicrobial and antiproliferative activities. Bioprocess Biosyst. Eng. 2018, 41, 939–951. [Google Scholar] [CrossRef] [PubMed]
- Rao, K.S.; Singh, T.; Kumar, A. Aqueous-mixed ionic liquid system: Phase transitions and synthesis of gold nanocrystals. Langmuir 2011, 27, 9261–9269. [Google Scholar] [CrossRef] [PubMed]
- Logeswari, P.; Silambarasan, S.; Abraham, J. Ecofriendly synthesis of silver nanoparticles from commercially available plant powders and their antibacterial properties. Sci. Iran. 2013, 20, 1049–1054. [Google Scholar]
- Terletskaya, N.V.; Seitimova, G.A.; Kudrina, N.O.; Meduntseva, N.D.; Ashimuly, K. The Reactions of Photosynthetic Capacity and Plant Metabolites of Sedum hybridum L. in Response to Mild and Moderate Abiotic Stresses. Plants 2022, 11, 828. [Google Scholar] [CrossRef] [PubMed]
- Cardoso-Avila, P.E.; Patakfalvi, R.; Rodríguez-Pedroza, C.; Aparicio-Fernández, X.; Loza-Cornejo, S.; Villa-Cruz, V.; Martínez-Cano, E. One-pot green synthesis of gold and silver nanoparticles using: Rosa canina L. extract. RSC Adv. 2021, 11, 14624–14631. [Google Scholar] [CrossRef] [PubMed]
- Singh, P.; Singh, H.; Ahn, S.; Castro-Aceituno, V.; Jiménez, Z.; Simu, S.Y.; Kim, Y.J.; Yang, D.C. Pharmacological importance, characterization and applications of gold and silver nanoparticles synthesized by Panax ginseng fresh leaves. Artif. Cells Nanomed. Biotechnol. 2017, 45, 1415–1424. [Google Scholar] [CrossRef] [PubMed]
- Prakash, P.; Gnanaprakasam, P.; Emmanuel, R.; Arokiyaraj, S.; Saravanan, M. Green synthesis of silver nanoparticles from leaf extract of Mimusops elengi, Linn. for enhanced antibacterial activity against multi drug resistant clinical isolates. Colloids Surf. B. Biointerfaces 2013, 108, 255–259. [Google Scholar] [CrossRef]
- Ibrahim, H.M.M. Green synthesis and characterization of silver nanoparticles using banana peel extract and their antimicrobial activity against representative microorganisms. J. Radiat. Res. Appl. Sci. 2015, 8, 265–275. [Google Scholar] [CrossRef]
- Jahan, I.; Erci, F.; Isildak, I. Rapid green synthesis of non-cytotoxic silver nanoparticles using aqueous extracts of ‘Golden Delicious’ apple pulp and cumin seeds with antibacterial and antioxidant activity. SN Appl. Sci. 2021, 3, 94. [Google Scholar] [CrossRef]
- Alwhibi, M.S.; Soliman, D.A.; Awad, M.A.; Alangery, A.B.; Al Dehaish, H.; Alwasel, Y.A. Green synthesis of silver nanoparticles: Characterization and its potential biomedical applications. Green Process. Synth. 2021, 10, 412–420. [Google Scholar] [CrossRef]
- Christopher, J.S.G.; Saswati, B.; Ezilrani, P.S. Optimization of parameters for biosynthesis of silver nanoparticles using leaf extract of Aegle marmelos. Braz. Arch. Biol. Technol. 2015, 58, 702–710. [Google Scholar] [CrossRef]
- Gouyau, J.; Duval, R.E.; Boudier, A.; Lamouroux, E.; Gouyau, J.; Duval, R.E.; Boudier, A.; Lamouroux, E.; Banti, C.N.; Rossos, A.K. Investigation of Nanoparticle Metallic Core Antibacterial Activity: Gold and Silver Nanoparticles against Escherichia coli and Staphylococcus aureus. Int. J. Mol. Sci. 2021, 22, 1905. [Google Scholar] [CrossRef] [PubMed]
- Holt, K.B.; Bard, A.J. Interaction of silver(I) ions with the respiratory chain of Escherichia coli: An electrochemical and scanning electrochemical microscopy study of the antimicrobial mechanism of micromolar Ag+. Biochemistry 2005, 44, 13214–13223. [Google Scholar] [CrossRef] [PubMed]
- Rahaman Mollick, M.M.; Bhowmick, B.; Mondal, D.; Maity, D.; Rana, D.; Dash, S.K.; Chattopadhyay, S.; Roy, S.; Sarkar, J.; Acharya, K.; et al. Anticancer (in vitro) and antimicrobial effect of gold nanoparticles synthesized using Abelmoschus esculentus (L.) pulp extract via a green route. RSC Adv. 2014, 4, 37838–37848. [Google Scholar] [CrossRef]
- Castillo-Henríquez, L.; Alfaro-Aguilar, K.; Ugalde-álvarez, J.; Vega-Fernández, L.; de Oca-Vásquez, G.M.; Vega-Baudrit, J.R. Green synthesis of gold and silver nanoparticles from plant extracts and their possible applications as antimicrobial agents in the agricultural area. Nanomaterials 2020, 10, 1763. [Google Scholar] [CrossRef]
- Nikaeen, G.; Yousefinejad, S.; Rahmdel, S.; Samari, F.; Mahdavinia, S. Central Composite Design for Optimizing the Biosynthesis of Silver Nanoparticles using Plantago major Extract and Investigating Antibacterial, Antifungal and Antioxidant Activity. Sci. Rep. 2020, 10, 9642. [Google Scholar] [CrossRef]
- Lotfy, W.A.; Alkersh, B.M.; Sabry, S.A.; Ghozlan, H.A. Biosynthesis of silver nanoparticles by Aspergillus terreus: Characterization, optimization, and biological activities. Front. Bioeng. Biotechnol. 2021, 9, 633468. [Google Scholar] [CrossRef]
- Shah, M.Z.; Guan, Z.H.; Din, A.U.; Ali, A.; Rehman, A.U.; Jan, K.; Faisal, S.; Saud, S.; Adnan, M.; Wahid, F.; et al. Synthesis of silver nanoparticles using Plantago lanceolata extract and assessing their antibacterial and antioxidant activities. Sci. Rep. 2021, 111, 20754. [Google Scholar] [CrossRef]
- Rodríguez-León, E.; Rodríguez-Vázquez, B.E.; Martínez-Higuera, A.; Rodríguez-Beas, C.; Larios-Rodríguez, E.; Navarro, R.E.; López-Esparza, R.; Iñiguez-Palomares, R.A. Synthesis of Gold Nanoparticles Using Mimosa tenuiflora Extract, Assessments of Cytotoxicity, Cellular Uptake, and Catalysis. Nanoscale Res. Lett. 2019, 14, 334. [Google Scholar] [CrossRef]
- Wang, C.; Mathiyalagan, R.; Kim, Y.J.; Castro-Aceituno, V.; Singh, P.; Ahn, S.; Wang, D.; Yang, D.C. Rapid green synthesis of silver and gold nanoparticles using Dendropanax morbifera leaf extract and their anticancer activities. Int. J. Nanomed. 2016, 11, 3691–3701. [Google Scholar]
- Suliman, Y.A.O.; Ali, D.; Alarifi, S.; Harrath, A.H.; Mansour, L.; Alwasel, S.H. Evaluation of cytotoxic, oxidative stress, proinflammatory and genotoxic effect of silver nanoparticles in human lung epithelial cells. Environ. Toxicol. 2015, 30, 149–160. [Google Scholar] [CrossRef]
- Delalat, R.; Sadat Shandiz, S.A.; Pakpour, B. Antineoplastic effectiveness of silver nanoparticles synthesized from Onopordum acanthium L. extract (AgNPs-OAL) toward MDA-MB231 breast cancer cells. Mol. Biol. Rep. 2022, 49, 1113–1120. [Google Scholar] [CrossRef]
- Jacob, S.J.P.; Finub, J.S.; Narayanan, A. Synthesis of silver nanoparticles using Piper longum leaf extracts and its cytotoxic activity against Hep-2 cell line. Colloid Surf. B Biointerfaces 2012, 91, 212–214. [Google Scholar] [CrossRef]
- Majumdar, M.; Biswas, S.C.; Choudhury, R.; Upadhyay, P.; Adhikary, A.; Roy, D.N.; Misra, T.K. Synthesis of Gold Nanoparticles Using Citrus macroptera Fruit Extract: Anti-Biofilm and Anticancer Activity. ChemistrySelect 2019, 4, 5714–5723. [Google Scholar] [CrossRef]
- Sohaebuddin, S.K.; Thevenot, P.T.; Baker, D.; Eaton, J.W.; Tang, L. Nanomaterial cytotoxicity is composition, size, and cell type dependent. Part. Fibre Toxicol. 2010, 7, 22. [Google Scholar] [CrossRef] [PubMed]
- Laban, B.; Ralević, U.; Petrović, S.; Leskovac, A.; Vasić-Anićijević, D.; Marković, M.; Vasić, V. Green synthesis and characterization of nontoxic L-methionine capped silver and gold nanoparticles. J. Inorg. Biochem. 2020, 204, 110958. [Google Scholar] [CrossRef] [PubMed]
- Daisy, P.; Saipriya, K. Biochemical analysis of Cassia fistula aqueous extract and phytochemically synthesized gold nanoparticles as hypoglycemic treatment for diabetes mellitus. Int. J. Nanomed. 2012, 7, 1189–1202. [Google Scholar] [CrossRef] [PubMed]
- Bapolisi, A.M.; Nkanga, C.I.; Walker, R.B.; Krause, R.W.M. Simultaneous liposomal encapsulation of antibiotics and proteins: Co-loading and characterization of rifampicin and Human Serum Albumin in soy-liposomes. J. Drug Deliv. Sci. Technol. 2020, 58, 101751. [Google Scholar] [CrossRef]
- Nkanga, C.I.; Krause, R.W.; Noundou, X.S.; Walker, R.B. Preparation and characterization of isoniazid-loaded crude soybean lecithin liposomes. Int. J. Pharm. 2009, 526, 466–473. [Google Scholar] [CrossRef]
- Zia, F.; Ghafoor, N.; Iqbal, M.; Mehboob, S. Green synthesis and characterization of silver nanoparticles using Cydonia oblong seed extract. Appl. Nanosci. 2016, 6, 1023–1029. [Google Scholar] [CrossRef]
- Cheng, Y.; Wei, Y.; Fang, C.; Chen, J.; Zhao, W. Facile synthesis of CQDs/Ag NPs composites with photoluminescence and their potential application in antibacterial materials. Inorg. Chem. Commun. 2021, 134, 109059. [Google Scholar] [CrossRef]
- Fafal, T.; Taştan, P.; Tüzün, B.S.; Ozyazici, M.; Kivcak, B. Synthesis, characterization and studies on antioxidant activity of silver nanoparticles using Asphodelus aestivus Brot. aerial part extract. S. Afr. J. Bot. 2017, 112, 346–353. [Google Scholar] [CrossRef]
- Nakkala, J.R.; Mata, R.; Bhagat, E.; Sadras, S.R.; Nakkala, J.R.; Mata, R.; Bhagat, E.; Sadras, S.R. Green synthesis of silver and gold nanoparticles from Gymnema sylvestre leaf extract: Study of antioxidant and anticancer activities. J. Nanopart. Res. 2015, 17, 151. [Google Scholar] [CrossRef]

| Sr. No | Components | Antibacterial Activity in the Zone of Inhibition (mm) | Antifungal Activity | Antioxidant Activity | ||||||||
|---|---|---|---|---|---|---|---|---|---|---|---|---|
| ST | SE | SD | EC | YE | YS | CD | CA | CT | CG | DPPH (%) | ||
| 1 | SP extract | − | − | − | − | − | − | − | − | − | − | 38 |
| 2 | SP-AuNPs | + | − | + | w | w | +++ | ++ | + | + | − | 41 |
| 3 | SP-AgNPs | + | + | + | + | + | ++ | − | − | − | − | 43 |
Disclaimer/Publisher’s Note: The statements, opinions and data contained in all publications are solely those of the individual author(s) and contributor(s) and not of MDPI and/or the editor(s). MDPI and/or the editor(s) disclaim responsibility for any injury to people or property resulting from any ideas, methods, instructions or products referred to in the content. |
© 2023 by the authors. Licensee MDPI, Basel, Switzerland. This article is an open access article distributed under the terms and conditions of the Creative Commons Attribution (CC BY) license (https://creativecommons.org/licenses/by/4.0/).
Share and Cite
Kuppusamy, P.; Kim, S.; Kim, S.-J.; Park, M.; Song, K.-D. Sedeveria pink ruby Extract-Mediated Synthesis of Gold and Silver Nanoparticles and Their Bioactivity against Livestock Pathogens and in Different Cell Lines. Antibiotics 2023, 12, 507. https://doi.org/10.3390/antibiotics12030507
Kuppusamy P, Kim S, Kim S-J, Park M, Song K-D. Sedeveria pink ruby Extract-Mediated Synthesis of Gold and Silver Nanoparticles and Their Bioactivity against Livestock Pathogens and in Different Cell Lines. Antibiotics. 2023; 12(3):507. https://doi.org/10.3390/antibiotics12030507
Chicago/Turabian StyleKuppusamy, Palaniselvam, Sujung Kim, Sung-Jo Kim, Myunghum Park, and Ki-Duk Song. 2023. "Sedeveria pink ruby Extract-Mediated Synthesis of Gold and Silver Nanoparticles and Their Bioactivity against Livestock Pathogens and in Different Cell Lines" Antibiotics 12, no. 3: 507. https://doi.org/10.3390/antibiotics12030507
APA StyleKuppusamy, P., Kim, S., Kim, S.-J., Park, M., & Song, K.-D. (2023). Sedeveria pink ruby Extract-Mediated Synthesis of Gold and Silver Nanoparticles and Their Bioactivity against Livestock Pathogens and in Different Cell Lines. Antibiotics, 12(3), 507. https://doi.org/10.3390/antibiotics12030507

